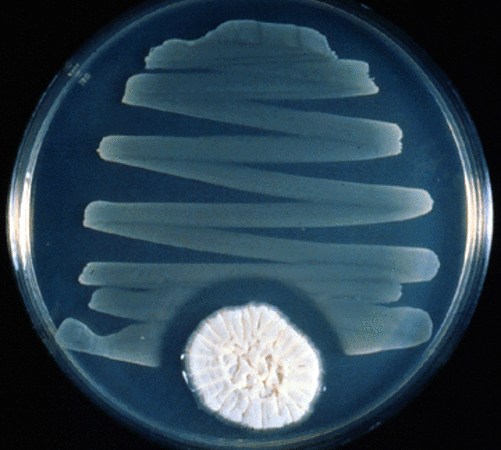

Healing The Earth Without Government by Wes Annac
Some of us are convinced this is one of the only ways to restore the world to its once pristine condition, but it isn’t. Like we’ve been exploring in this segment, there are plenty of big and small things we can do to heal the earth and we don’t need to get the […]